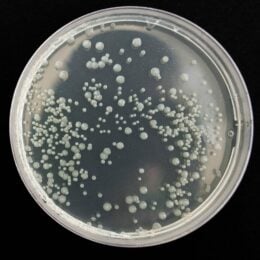
TSA-bakteeri- ja sädesienitesti

Allergiatestit
osastot
Allergiatestit ovat yksi tapa tarkastella kehon ja ympäristön välisiä vuorovaikutuksia silloin, kun arjessa herää kysymyksiä omasta hyvinvoinnista. Ne liittyvät tilanteisiin, joissa halutaan ymmärtää paremmin mahdollisia herkistymisiä, ravintoon liittyviä yksilöllisiä eroja tai kodin ja muun sisäympäristön olosuhteita. Testit eivät ole diagnooseja, vaan ne tarjoavat taustatietoa, joka voi auttaa jäsentämään kokonaiskuvaa omasta tilanteesta. Allergiatestien yhteydessä korostuu huolellinen testaus ja ohjeiden noudattaminen, jotta testin käyttötarkoitus vastaa mahdollisimman hyvin tiedontarvetta.
Milloin allergiatestit voi olla ajankohtainen?
• Kun esiintyy toistuvia tai vaikeasti selitettäviä oireita arjessa
• Kun halutaan kartoittaa mahdollisia ravintoon tai ympäristöön liittyviä herkistymisiä
• Kun kiinnostus kohdistuu ravitsemuksen yksilöllisiin eroihin ja kehon tapaan käsitellä ravintoaineita
• Kun sisätilojen olosuhteet, kuten kodin pinnat tai ilmanlaatu, herättävät kysymyksiä
• Kun omaa hyvinvointia halutaan tarkastella ennakoivasti ja tiedon pohjalta
Valikoimasta löytyy erilaisiin käyttötarkoituksiin soveltuvia allergiatestejä, mukaan lukien ravitsemukseen liittyviä geenitestejä sekä sisäilmaan ja pintoihin kohdistuvia testejä. Kunkin testin omalta sivulta löytyy tarkempi kuvaus siitä, mihin käyttöön testi on tarkoitettu ja miten se suoritetaan. Testikohtaisiin ohjeisiin tutustuminen on tärkeä osa luotettavaa ja tarkoituksenmukaista testausta.